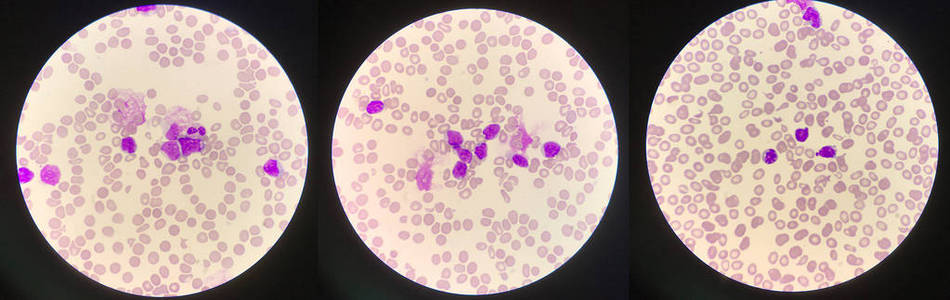
白血病细胞图片

无颗粒白细胞

白细胞,显微镜,水平画幅,无人,白血病
图片尺寸1200x900
白细胞,显微镜,水平画幅,无人,白血病
图片尺寸1200x900
北京广济中医院血液科-化疗后血象下降通常是白细胞"优先"
图片尺寸500x385
请你看白细胞
图片尺寸1080x1081
白血病细胞图片
图片尺寸950x300
图片浏览
图片尺寸200x188
镜下白细胞辨别
图片尺寸2048x1536
一组大量白细胞,但干化学一个 的尿液沉渣以及染色
图片尺寸1281x961
白细胞数量突然骤降,原因为何?
图片尺寸277x381
最易漏诊的白血病——低白m3|骨髓|粒细胞|白细胞_网易订阅
图片尺寸541x440
白细胞数量突然骤降,原因为何?
图片尺寸271x378
为什么有些疾病引起白细胞增多?
图片尺寸1200x900
末梢血涂片染色镜检:(仪器分析:白细胞计数减少,贫血,血小板计数减少
图片尺寸432x446
白血病的异常细胞治疗溃疡卷心菜富含维生素u这是一种"溃疡愈合因子"
图片尺寸600x400
白细胞,主要是排除从外部入侵到体内的细菌和病毒等异物.
图片尺寸1280x1049
白细胞骤降结果能不能发
图片尺寸392x385
白细胞低发热怎么回事 白细胞主要特点有哪些
图片尺寸390x249
白细胞(白细胞)
图片尺寸1100x1100
医学科普| 白细胞是一种无色的血细胞 为何要叫白细胞?
图片尺寸800x600
白细胞
图片尺寸1200x800